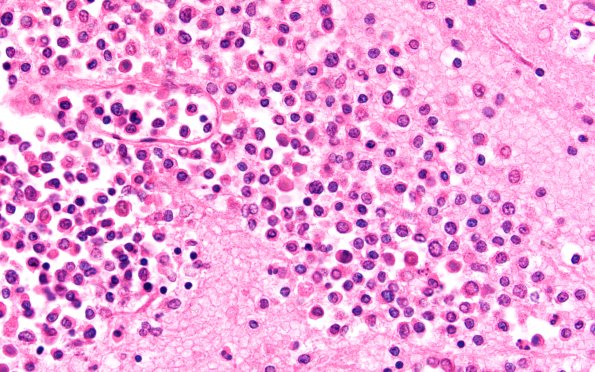
4B2C  Case 4F 60X

Table of Contents
Washington University Experience | NEOPLASMS (HEMATOLYMPHOID) | Granulocytic Sarcoma | 4B2C Case 4F 60X
Multiple hemorrhages appreciated grossly in cerebral cortex and brainstem prove on microscopic examination to consist of a rim of fresh hemorrhage surrounding a pure collection of white cells most of which appear to be myeloblasts. These lesions have a predilection for the area of the grey-white junction